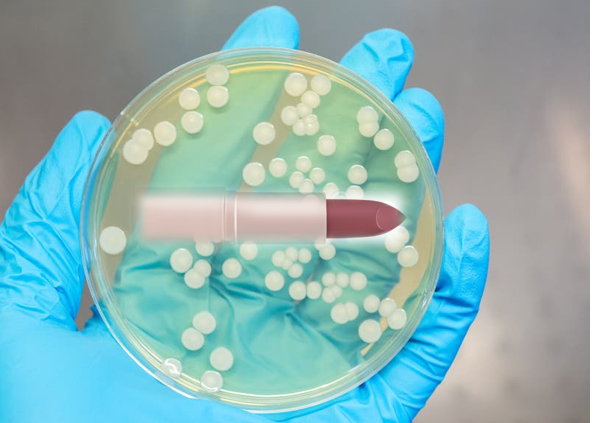

Le rouge à lèvres fait de la résistance !
Il y a ceux qui rêvent de transformer le rouge à lèvres en une arme antimicrobienne,1 en y introduisant des actifs antiseptiques au spectre d’action large (c’est pas bien, car un cosmétique doit respecter sa définition réglementaire et ne pas flirter avec le domaine médical !).
Il y a ceux qui traquent les substances et contenus incongrus dans les cosmétiques et réalisent, des signalements par le biais de la littérature scientifique… Evidemment, c’est très bien. Très bien de montrer, qu’il est possible de trouver, dans certaines références du marché, dans certains pays, des choses pour le moins originales.
Dans un rouge à lèvres, par exemple… il est possible, parfois, de mettre en évidence des germes ou bien des antibiotiques…
Les testeurs de produits de maquillage, des produits qui résistent mal à la contamination
Une publication d’août 2025 nous montre à quel point il n’est pas judicieux d’utiliser sur sa peau ou ses lèvres les testeurs de produits de maquillage, mis à disposition dans les enseignes de produits de beauté. Il y a, en effet, une certaine probabilité pour que le produit en question renferme quelques germes à sa façon, acquis vraisemblablement, en magasin, lors des tests effectués par la clientèle. On peut y retrouver, par exemple, des germes comme Bacillus mojavensis, Staphylococcus haemolyticus, Bacillus subtilis, Bacillus cereus, Bacillus pumilus, Bacillus amyloliquefaciens, Staphylococcus warneri… avec dans certains cas des souches résistantes aux antibiotiques,2 ce qui est loin d’être rassurant.
Certains produits de maquillage, des produits contaminés par des germes
Une publication de mai 2023 envoie un pavé dans la mare… de l’industrie cosmétique du Bangladesh, puisque les auteurs nous disent que les produits cosmétiques y sont produits dans le mépris total des BPF. Dans ces conditions, on n’est pas étonné de retrouver différents germes dans les produits prélevés sur le marché. Des bactéries à Gram négatif (Escherichia coli, Pseudomonas aeruginosa, Klebsiella pneumoniae et Salmonella spp.) et d’autres à Gram positif (espèces de Streptococcus, Staphylococcus, Bacillus et Listeria monocytogenes) ont ainsi été caractérisées. Leur résistance et même leur multi-résistance aux antibiotiques a également été démontrée.3
Certains produits de maquillage, des produits contaminés par des antibiotiques
Une publication chinoise d’octobre 2025 signalant la présence potentielle de sulfamides dans des rouges à lèvres4 a de quoi intriguer. Il s’agit, nous dit-on, de rouges à lèvres illégaux formulés avec des sulfamides, afin d’en accroitre l’efficacité. L’efficacité ? Etrange, lorsque l’on sait qu’un rouge à lèvres a pour but de colorer les lèvres et non de traiter une quelconque infection.
Le rouge à lèvres fait de la résistance, en bref
Ce cosmétique résiste parfois aux Bonnes Pratiques de Fabrication. Il en sort alors souillé par des germes microbiens.
Ce cosmétique résiste parfois aux Bonnes Pratiques de Conservation… Il en sort alors souillé par les micro-organismes déposés par le client précédent (on pense ici au cas des testeurs mis à disposition du public).
Ce cosmétique résiste parfois au bon sens… Il en sort alors souillé par des ingrédients comme des antibiotiques qui n’ont rien à faire dans sa composition !
Bref, un cosmétique qui résiste aux modes et au temps mais résiste mal à une fabrication ou à une conservation défectueuse.
Bibliographie
1 Tuñón-Molina A, Cano-Vicent A, Serrano-Aroca Á. Antimicrobial Lipstick: Bio-Based Composition against Viruses, Bacteria, and Fungi. ACS Appl Mater Interfaces. 2022 Dec 28;14(51):56658-56665
2 Bedaida IK, Bendjama E, Chelaghma W, Zouzou A, Benabderrahmane H, Rolain JM, Loucif L. Makeup testers as reservoirs and transmission sources of antibiotic resistant bacteria. Infect Dis Health. 2025 Aug;30(3):211-216
3 Nusrat N, Ahmad Zahra M, Ahmed A, Haque F. Assessment of potential pathogenic bacterial load and multidrug resistance in locally manufactured cosmetics commonly used in Dhaka metropolis. Sci Rep. 2023 May 13;13(1):7787
4 Dai X, Zhu X, Li S, Wu Z, Zhao C, Gao X, Zhao L. Efficient extraction of two different sulfonamide antibiotics from lipstick by magnetic solid-phase extraction based on c-MMWCNT@CDs/Fe3O4. J Chromatogr A. 2025 Oct 11;1760:466266